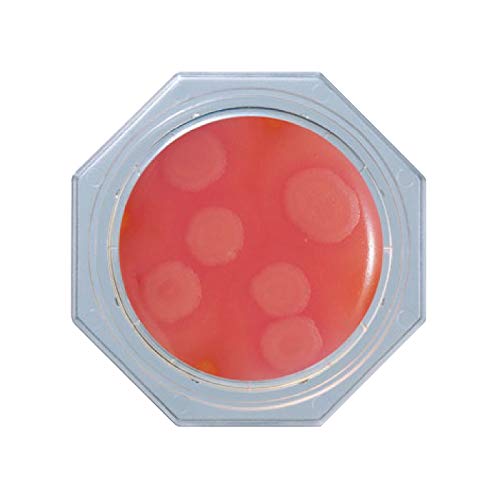
日水製薬 フードスタンプ 「ニッスイ」 セレウス寒天 (セレウス菌用) 30枚

販売情報
画面をスクロールすると販売情報が更新されます。
最終更新:
最安値ショップ
最安値ショッピングサイト
実質価格ランキング
商品情報






押しつけるだけでサンプリング。誰でも手軽に的確な検査が可能。 食品・環境衛生検査用 用途:食品真菌用 入数:1箱(5枚/袋×6袋入) 製品箱サイズ:10cm×28cm×6cm 重量:440g 保存方法:4~10℃(冷所・禁凍結) 有効期限:製造後12ヶ月 ※事業者向け商品です。ご使用後の培地類は、速やかにオートクレーブ滅菌後、地方自治体または国の法規に準拠し、安全に処分してください。
| JANコード | 4987302067558 |
|---|---|
| 型番 | 06755 |
| メーカー | 日水製薬 |
| ブランド | 日水製薬 |